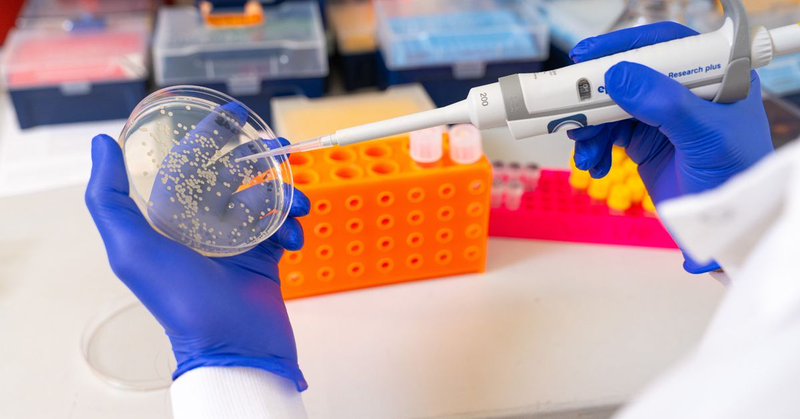
Tweet card summary image

Kolade Adebowale, Ph.D.
@KoladeAdebowal1
Followers
2K
Following
11K
Media
34
Statuses
928
Assistant Professor at UC San Diego Bioengineering (@ucsdbe). | He/him.
La Jolla, CA
Joined May 2020
1/2. I am thrilled that I'll start my dream job at UCSD Bioengineering @ucsdbe, @UCSDJacobs + @NIH_CommonFund FIRST faculty. Grateful for @SMitragotri and @theChaudhurilab's unwavering support. Hiring at all levels! #Viscoelasticity #Biomaterials #Mechanoimmunology #CellDynamics
113
113
1K
We had our inaugural "4th floor Friendsgiving". Many thanks to Drs. Vira Kravets and Erika Cyphert for helping organize. Love the Snoopy with a scarf background pic. Looking forward to growing our community of Bioengineers on the 4th floor. 😎 @ucsdbe
0
1
11
👇👇👇👇Just Released👇👇👇👇 The 2025 Impact Report for @UCSDJacobs's Chien-Lay Department of #Bioengineering is out!!!! Amazing updates from @ucsdbe students, faculty, and staff. #TritonPride
https://t.co/wfSWOTCvXD
heyzine.com
Created with the Heyzine flipbook maker
1
3
9
Had a fantastic time at the 2025 BMES annual conference, meeting, catching up, and celebrating mentors, friends, and students. #BMES2025.
1
3
31
🔬Join us on Oct 8, 2025, for this year’s Biomedical Engineering Innovation, Design, and Entrepreneurship Alliance (BME-IDEA) Meeting with @Venturewell Register today: https://t.co/vzGzOhf34r
0
1
4
Thank you, @prebysfound, for supporting our work to understand how physical cues regulate macrophage and T cell responses in diseases like cancer. These insights can help us maximize the clinical impact of macrophage- or T cell-targeting therapies. https://t.co/M1JHyZslnV
today.ucsd.edu
The UC San Diego School of Medicine announced the inaugural recipients of its pivot grant program, an initiative made possible by a $1 million gift from Prebys Foundation to help protect San Diego’s...
0
0
30
Please spread the word about this foundation dedicated to dilated cardiomyopathy caused by mutations in the LMNA gene. It helps connect patients and provide them with resources and connections to clinicians and researchers.
📣 We need your help! 💙 Download our flyer & spread the word about LMNA-related heart disease: ✅ Share online ✅ Hang in clinics & waiting rooms ✅ Send to your network Will you help us grow? 🌍 👉 https://t.co/AibixoV7uY
#LMNA #RareDisease #HeartHealth
1
11
27
First Kolade Lab social outing (mini-golf ⛳️then dinner). Starting a lab is tough, but this amazing and fearless crew (and incredible colleagues) has made it so much easier over the past four months! @ucsdbe @UCSDJacobs @UCSD.
1
6
169
Thrilled that our newest work led by @AveryTTran, Dr. Wisniewski, and @mistrigr is out today in @NatureMaterials! We show how the cytokinesis proteins Anillin and Ect2 drive RhoA/ROCK/myosin-mediated invasion in confining spaces in vitro and in vivo. https://t.co/HXCOZmcXKv.
nature.com
Nature Materials - Cell migration in confined environments is initiated by a cytoplasmic pool of anillin and Ect2 that promotes RhoA/myosin II-mediated activation at the poles of migrating cells,...
3
11
32
🚨 We’re hiring! The Synthetic Regeneration & Systems Physiology Lab (@SynRegLab) is seeking a full-time research technician to join our team. If you're passionate about single cell biology, gene editing, or wound repair—we’d love to hear from you!
woappilab.com
Research Technician position in wound physiology We are looking for a talented and motivated research technician to lead our efforts in the development of in vivo and in vitro wound models and skin...
0
11
22
New paper! Fast matrix stress relaxation potentiates human monocyte 3D migration by generating protrusive forces and is dependent on the Cdc42-WASp axis. Thanks to our amazing collaborators! #viscoelasticity #mechanobiology @theChaudhurilab @Stanford_ChEMH
https://t.co/wR7HVrnITC
pnas.org
Circulating monocytes are recruited to the tumor microenvironment, where they can differentiate into macrophages that mediate tumor progression. To...
3
12
56
Notice of Short-Term Extension to Early-Stage Investigator (ESI) Eligibility Period
0
49
77
Our new review on the mechanoregulation of cytotoxic lymphocytes is out in Nature Reviews Immunology! https://t.co/CydMipGnUp
nature.com
Nature Reviews Immunology - Cytotoxic T lymphocytes and natural killer cells destroy target cells using a mechanically active cytolytic immune synapse. This Review examines the various ways in...
1
4
19
Great catching up with our @ucsdbe seminar speaker, Professor Darrell Irvine, and our colleagues from @UCSDJacobs. Thanks for the photo idea Professor @StimulatedRaman 🙏!
0
1
31
We had a great time celebrating our one-month anniversary at @ucsdbe with Dr. @KravetsVira's and Dr. Xiaohua Huang's labs, and Isgard Hueck. Special thanks to @KravetsVira lab for the amazing lab swag including a gift of a very studious cytotoxic T cell mascot (to be named!)
0
1
30
We talked to Assistant Professor, Dr. Kolade Adebowale and his research focus of Mechano-immunology🧫 You can learn more about his journey into bioengineering on our instagram @ucsdbioengineering!
0
5
42
Our lab doors opened on Monday @ucsdbe and we had lab lunch today! Very excited to have three grad students (Sophia, Ruturaj, and Xiaoya) and one undergrad (Josie) rotating. More of our scientific adventures to come😎!
12
8
215
Great catching up with my friend @hara_toshiro from @umichmedicine and meeting Prof. Gerald Pao from the Okinawa Institute of Science and Technology (OIST) in San Diego.
0
0
8
Grateful for the opportunity to present the work that my Lab is doing @BrighamSurgery @DFCI_BreastOnc @harvardmed to target macrophages, which has led to a new clinical trial for breast cancer patients. Proud of my incredible team.
8
15
310
Thanks @GrifnoGabrielle (& @GordonConf staff) for being excellent partners in the planning & execution of the 2025 GRS Physical Science of Cancer 🙏! And congrats to our 2027 GRS Co-Chairs Sarah Henretta & Amrapali Datta as they lead us into an exciting future. #POC_GRC_2025
0
2
32